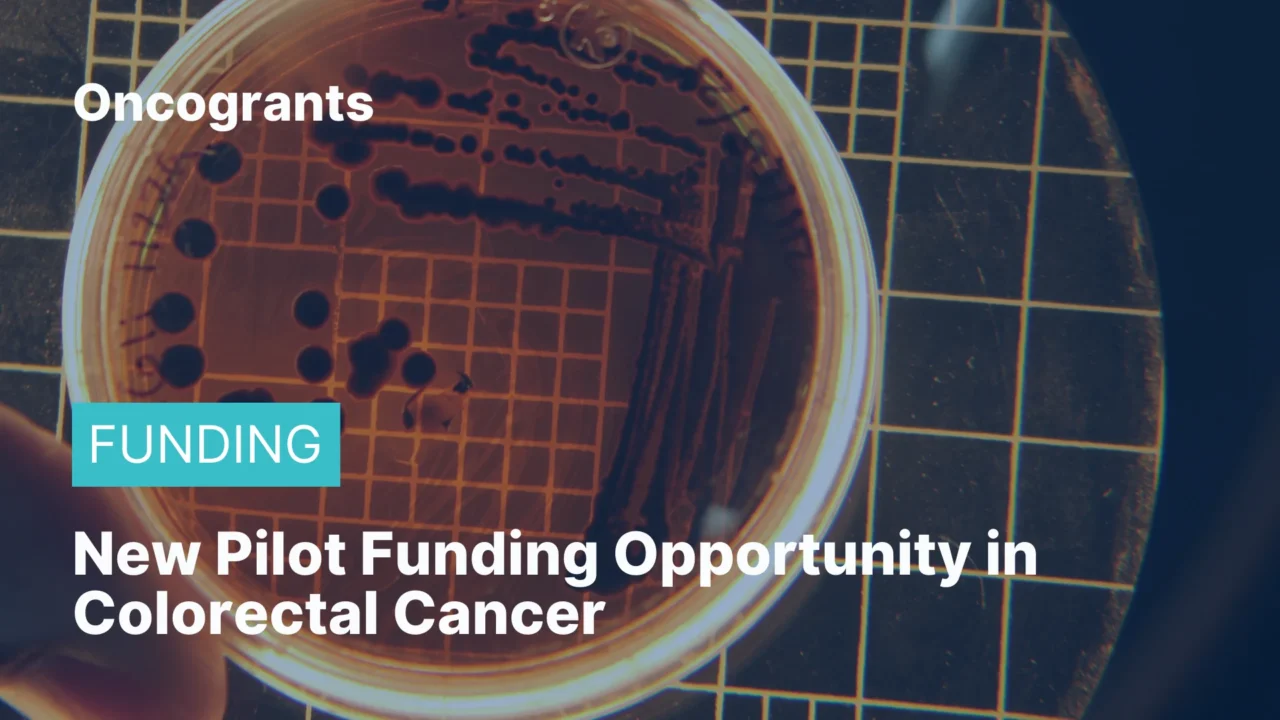
New Pilot Funding Opportunity in Colorectal Cancer (Johns Hopkins CRC CORE)

Johns Hopkins’ Colorectal Cancer Center of Research Excellence (CRC CORE) is offering pilot funding for novel developmental colorectal cancer research programs with translational potential. The goal is to support projects that lack sufficient preliminary data for a peer‑reviewed external grant. Projects are evaluated on potential impact, feasibility within one year, and plans to leverage results for larger external funding. Two awards are available in this cycle.
Eligibility Criteria:
- Open to faculty, including research associates.
Funding Details:
- $60,000 each for 1 year.
- 2 awards anticipated.
- No faculty salary support.
Deadline:
- Application due: Monday, March 2, 2026 (8:00 am).
- Funding decisions announced by: April 3, 2026.
- Funding period starts: May 1, 2026.
Where to go for further information:
- Submit application (collated PDF) to: nilo.azad@jhu.edu.
- Questions: nilo.azad@jhu.edu; eroberts@jhmi.edu.
- Program details.